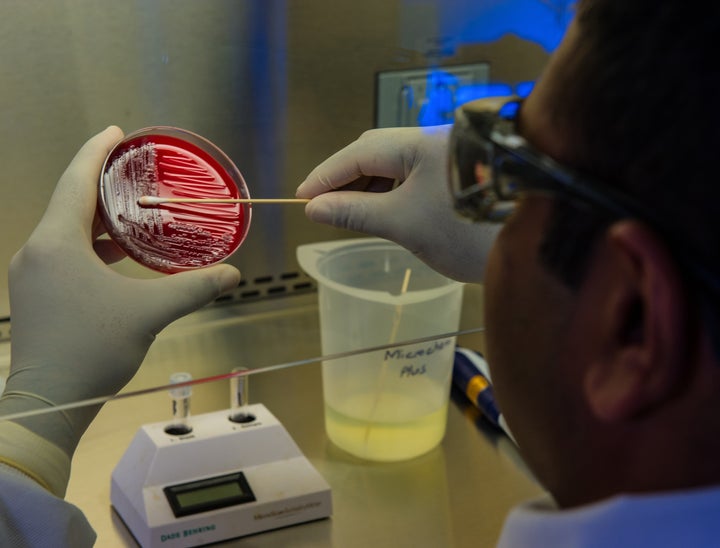

Interview Questions
Betterteam has interview questions for thousands of jobs. Prepare quickly for any interview with our guides.
Patrol Officer Interview Questions
Top 5 patrol officer interview questions with detailed tips for both hiring managers and candidates.
Quantitative Researcher Interview Questions
Top 5 quantitative researcher interview questions with detailed tips for both hiring managers and candidates.
Patient Sitter Interview Questions
Top 5 patient sitter interview questions with detailed tips for both hiring managers and candidates.
Patent Paralegal Interview Questions
Top 5 patent paralegal interview questions with detailed tips for both hiring managers and candidates.
Qualitative Researcher Interview Questions
Top 5 qualitative researcher interview questions with detailed tips for both hiring managers and candidates.
Meteorologist Interview Questions
Top 5 meteorologist interview questions with detailed tips for both hiring managers and candidates.
Microbiologist Interview Questions
Top 5 microbiologist interview questions with detailed tips for both hiring managers and candidates.
Patient Representative Interview Questions
Top 5 patient representative interview questions with detailed tips for both hiring managers and candidates.
Patent Lawyer Interview Questions
Top 5 patent lawyer interview questions with detailed tips for both hiring managers and candidates.
Patient Navigator Interview Questions
Top 5 patient navigator interview questions with detailed tips for both hiring managers and candidates.
Parent Coordinator Interview Questions
Top 5 parent coordinator interview questions with detailed tips for both hiring managers and candidates.
Patient Liaison Interview Questions
Top 5 patient liaison interview questions with detailed tips for both hiring managers and candidates.